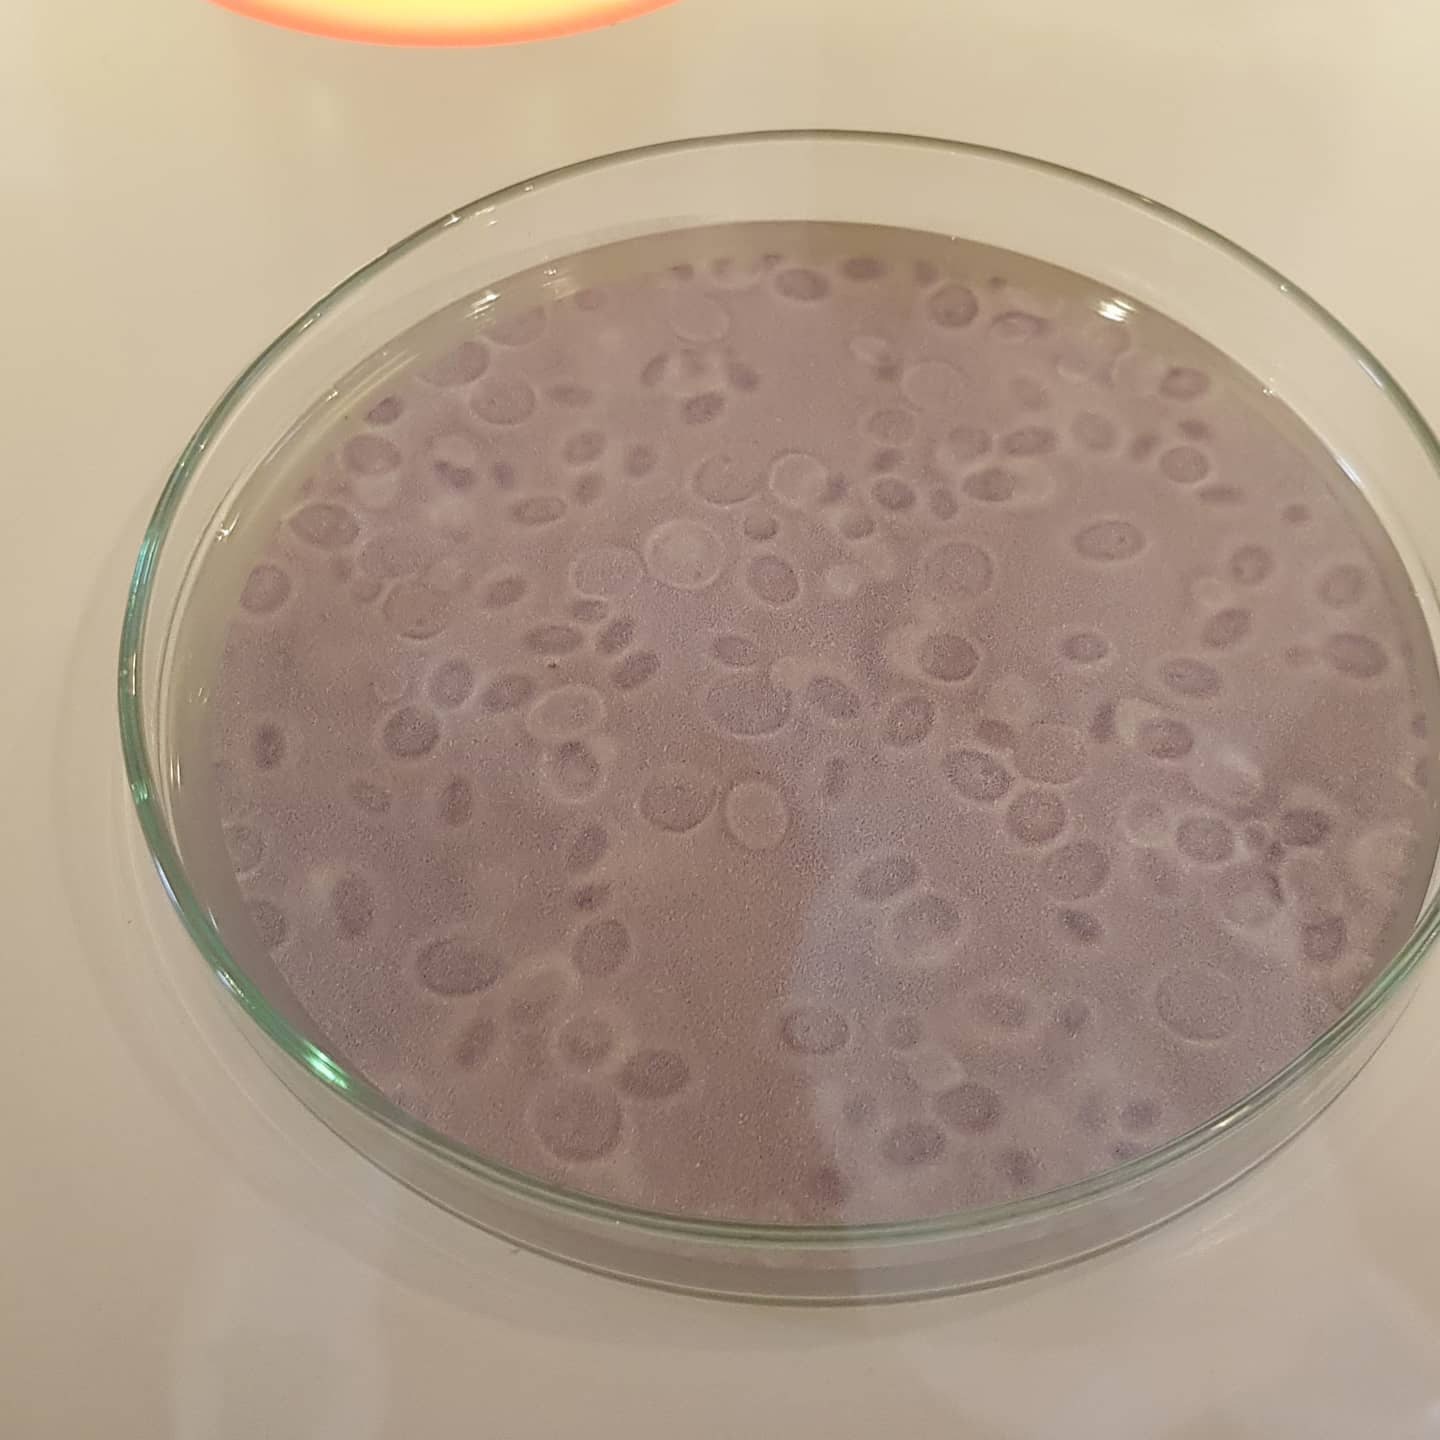

9.05 в 17.30 – Дегустация ПИВА, 2000р
Всех любителей и ценителей приглашаем на дегустацию пива 9 мая в 17.30 ч. Перепробуем все возможные и невозможные сорта: стауты, портеры, пилснеры, эли и т.д. Поговорим о технологии и пройдемся по Германии и Англии.
Будет весело и интересно, ждем в гости! Стоимость участия 2000 рублей, включая лекцию и закуски.
“Из разнообразия возникает совершенная гармония”.
Для тех, кто хочет посмотреть на пивоварение со всех сторон, добро пожаловать на дегустацию 9.05 в 17.30. Резерв по  915-31-94.
915-31-94.
Ждем в гости!
Свежие записи
- с 16 до 21ч, каждый день – ЛЕТНИЕ ДЕГУСТАЦИИ в легком формате, 1500р.
- 7.06 в 17.30 – Дегустация ШАРДОНЕ, 3500р.
- 11.06 в 18.00 – Дегустация РИСЛИНГА, 3500р.
- 14.06 в 17.30 – «БЕЛЫЙ СПЕКТР: от хрустящей свежести до пряного бархата», 3500р.
- 21.06 в 17.30 – Дегустация Италии, 3500р.
- 28.06 в 17.30 – «ЧИЛИ: за гранью привычных ожиданий», 3500р.
- 1.05 в 17.30 – Дегустация ИГРИСТЫХ вин, 3500р.
- 2.05 в 17.30 – “Хрустальные грани РИСЛИНГА”, 4000р.
- 3.05 в 17.30 – СОВИНЬОН БЛАН: Мировое турне по зеленым склонам”, 3500р.
- 8 и 22 мая в 19.00 – “ВИННЫЙ БЛЭКДЖЕК или игра вслепую”, 3500р.
- 9.05 в 17.30 – ДЕГУСТАЦИЯ РОССИИ, 2500р.
Архивы
- Июнь 2026
- Апрель 2026
- Март 2026
- Февраль 2026
- Январь 2026
- Декабрь 2025
- Ноябрь 2025
- Август 2025
- Июнь 2025
- Апрель 2025
- Март 2025
- Февраль 2025
- Январь 2025
- Декабрь 2024
- Ноябрь 2024
- Октябрь 2024
- Сентябрь 2024
- Август 2024
- Июль 2024
- Июнь 2024
- Май 2024
- Апрель 2024
- Март 2024
- Февраль 2024
- Январь 2024
- Октябрь 2023
- Август 2023
- Июль 2023
- Июнь 2023
- Май 2023
- Апрель 2023
- Март 2023
- Февраль 2023
- Январь 2023
- Октябрь 2022
- Сентябрь 2022
- Июль 2022
- Июнь 2022
- Май 2022
- Апрель 2022
- Февраль 2022
- Январь 2022
- Ноябрь 2021
- Октябрь 2021
- Сентябрь 2021
- Июнь 2021
- Май 2021
- Апрель 2021
- Март 2021
- Февраль 2021
- Январь 2021
- Ноябрь 2020
- Октябрь 2020
- Сентябрь 2020
- Март 2020
- Февраль 2020
- Январь 2020
- Ноябрь 2019
- Сентябрь 2019
- Август 2019
- Июль 2019
- Июнь 2019
- Май 2019
- Март 2019
- Январь 2019
- Декабрь 2018
- Ноябрь 2018
- Октябрь 2018
- Сентябрь 2018
- Август 2018
- Июль 2018
- Июнь 2018
- Май 2018
- Март 2018
- Февраль 2018
- Январь 2018
- Декабрь 2017
- Ноябрь 2017
- Октябрь 2017
- Апрель 2016
- Март 2016
- Февраль 2016
- Июль 2015
- Февраль 2015
- Январь 2015
В Classiсo проходят:
- Лекции
- Гастрономические вечера с дегустациями
- Встречи с сомелье
- Игры в дружной компании
Наши контакты:
Санкт-Петербург, ул. Типанова , д. 18
Мы открыты ср-вс с 11:00 до 22:00 пн,вт – выходные
Tel: +7 812 915-31-94
Mob: +7 905 217-27-77
E-mail: vinoteka.classico@yandex.ru
ООО “ВинДом”
ИНН 7810474146
Данный сайт не является интернет- магазином
События:
- с 16 до 21ч, каждый день – ЛЕТНИЕ ДЕГУСТАЦИИ в легком формате, 1500р.
- 7.06 в 17.30 – Дегустация ШАРДОНЕ, 3500р.
- 11.06 в 18.00 – Дегустация РИСЛИНГА, 3500р.
- 14.06 в 17.30 – «БЕЛЫЙ СПЕКТР: от хрустящей свежести до пряного бархата», 3500р.
- 21.06 в 17.30 – Дегустация Италии, 3500р.
- 28.06 в 17.30 – «ЧИЛИ: за гранью привычных ожиданий», 3500р.
- 1.05 в 17.30 – Дегустация ИГРИСТЫХ вин, 3500р.
- 2.05 в 17.30 – “Хрустальные грани РИСЛИНГА”, 4000р.
- 3.05 в 17.30 – СОВИНЬОН БЛАН: Мировое турне по зеленым склонам”, 3500р.
- 8 и 22 мая в 19.00 – “ВИННЫЙ БЛЭКДЖЕК или игра вслепую”, 3500р.
- 9.05 в 17.30 – ДЕГУСТАЦИЯ РОССИИ, 2500р.
- 10.05 в 17.30 – РОЗОВОЕ ВОССТАНИЕ: Путешествие по миру розовых вин, 3000р.
- 16.05 в 17.30 – Дегустация ВИНО и СЫР, 3500р